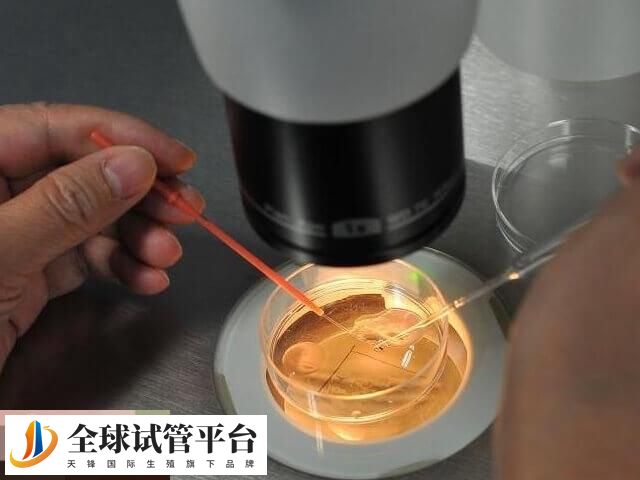
三代试管PGT技术包括多种检测类型

三代试管婴儿技术可通过胚胎植入前的染色体筛查,可以选择正常的胚胎植入,这样确实可以在一定程度上降低葡萄胎的发生风险。但并不能完全消除葡萄胎发生的可能性。毕竟pgt筛查技术存在一定的技术限制,并且葡萄胎的发生与多种因素有关,包括遗传、营养等,所以三代试管排除葡萄胎的几率并非百分百。
做三代试管婴儿会不会有葡萄胎
虽然三代试管移植前会进行胚胎筛查,一般医生会建议曾经有过葡萄胎经历的患者将胚胎发育到囊胚后再做筛查,确认染色体没有问题再移植,这样就能有效预防葡萄胎。但是葡萄胎的形成也不止由胚胎决定,所以三代试管无法完全避免。

而且要注意的是,葡萄胎出现的几率是不可控的,人为只能降低患有葡萄胎的风险,而没有办法做到0风险,但如果是从备孕的时候就开始对葡萄胎的风险进行控制,怀孕后出现这种情况的几率是很少的,如果说做试管的女性想要降低出现葡萄胎的几率,不妨选择在移植前对胚胎进行检查,这样能降低风险。
三代试管pgt筛查技术怎么样
三代试管PGT筛查技术(胚胎植入前遗传学检测)在预防遗传疾病和帮助高龄产妇等方面显示出显著优势。具体如下所示:
- 三代试管PGT技术包括多种检测类型,如PGT-A(针对染色体非整倍体的筛查)、PGT-M(针对单基因遗传病的筛查)和PGT-SR(针对染色体结构异常的筛查);
- 这些技术通过对胚胎的遗传学进行检测,筛选出健康的胚胎进行移植,从而降低遗传疾病的风险,提高妊娠成功率。






